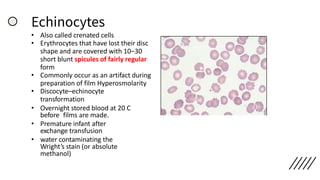
Echinocytes
• Also called crenated cells
• Erythrocytes that have lost their disc
shape and are covered with 10–30
short blunt spicules of fairly regular
form
• Commonly occur as an artifact during
preparation of film Hyperosmolarity
• Discocyte–echinocyte
transformation
• Overnight stored blood at 20 C
before films are made.
• Premature infant after
exchange transfusion
• water contaminating the
Wright’s stain (or absolute
methanol)
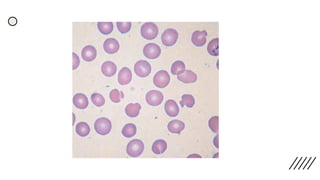
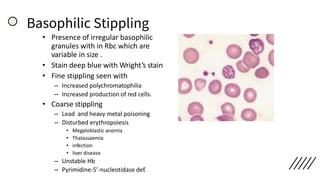
Basophilic Stippling
• Presence of irregular basophilic
granules with in Rbc which are
variable in size .
• Stain deep blue with Wright’s stain
• Fine stippling seen with
– Increased polychromatophilia
– Increased production of red cells.
• Coarse stippling
– Lead and heavy metal poisoning
– Disturbed erythropoiesis
• Megaloblastic anemia
• Thalassaemia
• infection
• liver disease
– Unstable Hb
– Pyrimidine-5’-nucleotidase def.
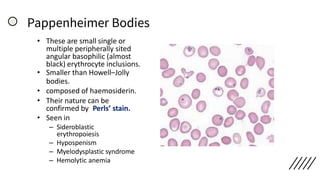
Pappenheimer Bodies
• These are small single or
multiple peripherally sited
angular basophilic (almost
black) erythrocyte inclusions.
• Smaller than Howell–Jolly
bodies.
• composed of haemosiderin.
• Their nature can be
confirmed by Perls’ stain.
• Seen in
– Sideroblastic
erythropoiesis
– Hypospenism
– Myelodysplastic syndrome
– Hemolytic anemia
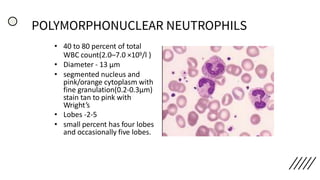
POLYMORPHONUCLEAR NEUTROPHILS
• 40 to 80 percent of total
WBC count(2.0–7.0 ×109/l )
• Diameter - 13 µm
• segmented nucleus and
pink/orange cytoplasm with
fine granulation(0.2-0.3µm)
stain tan to pink with
Wright’s
• Lobes -2-5
• small percent has four lobes
and occasionally five lobes.
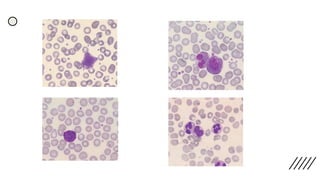
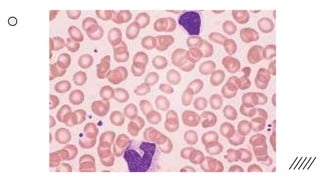
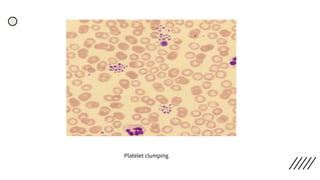
Platelet clumping
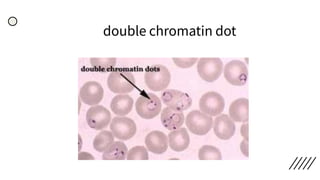
double chromatin dot

This document provides information on preparing and staining peripheral blood smears (PBS). It discusses how to make a wedge blood smear using the correct technique and equipment. It also describes how to evaluate a quality smear and identify common causes of poor smears. The document outlines the staining process for PBS, including the history and components of Romanowsky staining methods like Wright-Giemsa and May-Grunwald Giemsa. Factors that can influence staining and cause faulty results are discussed. Finally, it provides guidance on examining a PBS under the microscope, including evaluating red blood cells, white blood cells, platelets, and identifying any parasites.













![Brief History
• The beginnings of modern-day blood staining can be traced back to Ehrlich,
who in 1877, was the first scientist to divide the aniline dyes into acidic and
basic categories.
• Three years later , the malarial parasite was discovered, and a rigorous search
for an improved blood stain ensued – In 1888, Chenzinsky discovered a stain
composed of cationic dye methylene blue and anionic eosin.
• Malachowski modified that stain with a markedly improved color range
and depth
• Regrettably, when he published his results in Berlin in 1891, he did not give the
necessary details as to how his method might be reproduced.
• 3 weeks later the young Russian protozoologist Romanowsky published similar
findings in an article so celebrated that all future stains of analogous
composition were named as Romanowsky-type stains
[Romanowsky noted that a neglected, moldy methylene blue solution was more effective
in producing the desired red plasmodial chromatin bodies than was a fresh solution]](https://image.slidesharecdn.com/peripheralsmear-stainingandmorphology-200901120406/85/Peripheral-smear-staining-and-morphology-14-320.jpg)

![• Discrepancies in Red cell parameters –
Falsely high RBC –
a) Numerous large platelets
b) Hyperlipidaemia
c) Cryoglobulinemia/
Cryofibrinogenemia
Falsely Low RBC –
a) Cold agglutinins (Rarely warm
autoantibodies)
b) EDTA‐dependent pan-
agglutination
c) In vitro red cell lysis due to
mishandling of Extreme
microcytosis or fragmentation
Falsely high MCV –
a) Storage of blood at room
temperature
b) Cold agglutinins and EDTA‐
dependent pan-agglutinins
c) very high WBC count
d) Hyperosmolar states (e.g.
hypernatraemia, )
e) Excess K2EDTA
Falsely Low MCV –
a) Increase in ambient
temperature
b) Hypo‐osmolar states (e.g.
hyponatraemia
c) Repeated mixing of sample
leading to increased
oxygenation
Falsely high RBC
a) Poorly mixed specimen
b) High WBC
c) Hyperlipidaemia,
[endogenous or due to
parenteral nutrition]
d) hypergammaglobuline
mia](https://image.slidesharecdn.com/peripheralsmear-stainingandmorphology-200901120406/85/Peripheral-smear-staining-and-morphology-71-320.jpg)